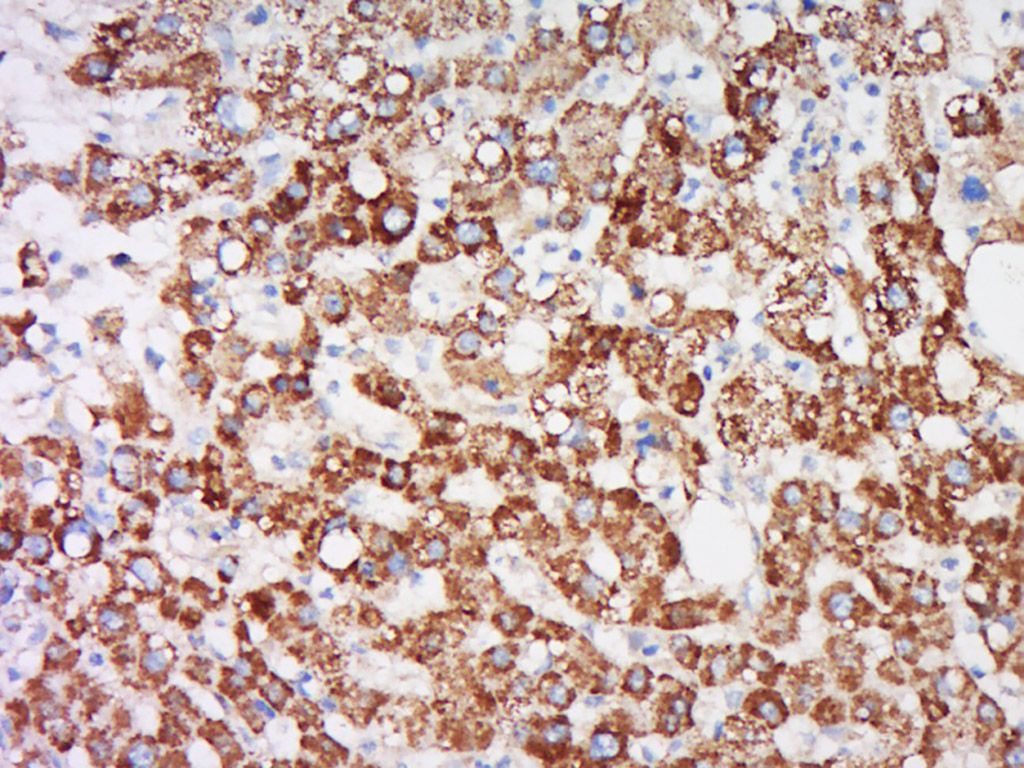

-
Product Name
Anti-SMYD2 antibody
- Documents
-
Description
Rabbit polyclonal antibody to SMYD2
-
Tested applications
WB, IHC-P
-
Species reactivity
Human, Mouse, Rat, Pig, Cow, Horse, Sheep
-
Alternative names
KMT3C antibody; HSKM-B antibody; ZMYND14 antibody
-
Isotype
Rabbit IgG
-
Preparation
This antigen of this antibody was klh conjugated synthetic peptide derived from human kmt3c 351-433/433
-
Clonality
Polyclonal
-
Formulation
Liquid, 0.01M TBS(pH7.4) with 1% BSA, 0.03% Proclin300 and 50% Glycerol.
-
Storage instructions
Store at -20℃ for one year. Avoid repeated freeze/thaw cycles. The lyophilized antibody is stable at room temperature for at least one month and for greater than a year when kept at -20℃. When reconstituted in sterile pH 7.4 0.01M PBS or diluent of antibody the antibody is stable for at least two weeks at 2-4℃.
-
Applications
WB:1:500-2000
IHC-P:1:400-800
-
Validations
Fig1: Tissue/cell: Human liver cancer; 4% Paraformaldehyde-fixed and paraffin-embedded;; Antigen retrieval: citrate buffer ( 0.01M, pH 6.0 ), Boiling bathing for 15min; Block endogenous peroxidase by 3% Hydrogen peroxide for 30min; Blocking buffer (normal goat serum,C-0005) at 37℃ for 20 min;; Incubation: Anti-KMT3C Polyclonal Antibody, Unconjugated 1:500, overnight at 4℃, followed by conjugation to the secondary antibody(SP-0023) and DAB(C-0010) staining

Fig2: Sample: heart (mouse) Lysate at 40 ug; Primary: Anti-KMT3C at 1/300 dilution; Secondary: IRDye800CW Goat Anti-Rabbit IgG at 1/20000 dilution; Predicted band size: 50 kD; Observed band size: 50 kD
- Background
Related Products / Services
Please note: All products are "FOR RESEARCH USE ONLY AND ARE NOT INTENDED FOR DIAGNOSTIC OR THERAPEUTIC USE"
